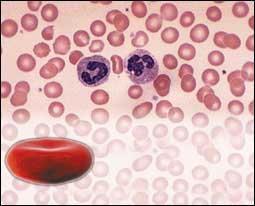

إزالتها لعبة مكشوفة تمارسها حكومة شارون المستوطنات الإسرائيلية ستدمر خارطة الطريق | 
* ديفيد ب. غرين(*)
بعد اجتماعات قمة شرم الشيخ والعقبة، فإن اؤلئك الذين يتحلون بالصبر على التفكير في مشكلات الإسرائيليين والفلسطينيين ربما يتساءلون: هل يوشك
السلام أن ينبثق؟ الإجابة هي بالنفي في الغالب.
الفلسطينيون لديهم قائد الآن اسمه محمود عباس يبدو واضحا أنه يقر بأن قرابة ثلاثة أعوام من الرعب لم ينجم عنها سوى الإضرار بقضيتهم، وهو يبدو
صادقا في محاولته وضع نهاية للانتفاضة، ويبدو أن ........التفاصيل |
|
رأي ثمن محاولة اغتيال الرنتيسي عوفير شيلح(*) | محاولة اغتيال عبد العزيز الرنتيسي، أحد قادة حركة حماس، هي ليست المرة الأولى التي تجري فيها عملية اغتيال، أو محاولة اغتيال، في الأيام التي يسود خلالها
الاعتقاد بأن الصراع يتحرك باتجاه خطوط سياسية.
هكذا حدث عندما أغتيل رائد الكرمي (الجهاز الأمني اعترف فيما بعد بأن اغتياله كان خاطئا)، وعندما اغتيل صلاح شحادة (رئيس هيئة الأركان العامة
للجيش الاسرائيلي قال بعد ذلك بأنه لم يعرف بأن المفاوضات التي ........التفاصيل |
|
شخصيات ومصطلحات صهيونية إسحق بن تزفي |
الرئيس الثاني لدولة إسرائيل ولد عام 1884 في بولتافا (روسيا) هاجرالى فلسطين عام 1907، تلقى دروسه الأولى في مدرسة عبرية، ثم دروسه الجامعية في
جامعة كييف (أوكرانيا)، درس القانون في جامعة اسطنبول، عمل على تنظيم الحركة العمالية اليهودية في منظمة الدفاع "هاشومر" التي أصبحت نواة
الهاغاناه.
ذهب الى الولايات المتحدة إثر نفيه من فلسطين عقب اندلاع الحرب العالمية الأولى، وعاد الى فلسطين عام 1917 وخدم في ........التفاصيل |
|
|
|
|
|
|
|
الفتاوى يجيب عنها الشيخ سلمان ابن فهد العودة * إعداد: ناصر الفهيد | هل يستطيع الجن أن يفض بكارة المرأة؟
* السؤال: هل يمكن للجني أن يفقد البنت عذريتها، أي: هل يمكن للجن أن يأتي للبنت في الحلم، ويعاشرها، ويفقدها عذريتها، مع العلم أن البنت أفاقت
من نومها، ووجدت دماء بعد حلم رأته في منامها؟
الجواب: أعتقد أن هذا غير ممكن، ولو فتحنا هذا الباب، لكان بمقدور أي إنسان أن يعتذر عن فعله، وما جرى له بأنه من فعل الجن، والناس مكلفون بما
هو في محيط عالم الشهادة، لا عالم ........التفاصيل |
|
|
|
|
|
تذكير واحد "شمّام"! عادل حوشان | عرضت إحدى القنوات العربية التلفزيونية "ريبورتاجا" عن خلية عمل المذيعات قبل نشرات الأخبار. وهن يتنقلن من غرف تبديل الملابس والماكياج وتناول
القهوة والاطلاع على آخر الأخبار، وانتقالهن خلف طاولة تقديم الأخبار المباشرة، هل يبدو الأمر طبيعيا؟ كانت إحدى المذيعات تلبس ملابس أنيقة لامرأة
تقدم نشرة أخبار، ودائما ماتقدم النشرة بنصفها العلوي، كانت مقدمة الأخبار الشهيرة تركض وتتبسم، خلاف تجهم وجوه ........التفاصيل |
|
المطار قراءة ثانية أسماك خارج الحوض | 
الحالات الشائكة والمتعددة على مستوى العالم التي يوجدها المطار فينا لا يمكن الوصول لها بسهولة بالرغم من أن البحث في العلبة سيخرج لنا أسماكاً صغيرة
تشبه الساردين بعضها مغمض وآخر يفتح عينيه بدهشة في ماء الجسد حين ننظر إليه ونكتشفه؟ بدءاً من الأثواب التي نلبسها والنساءالمحتفلات بعيون مكحلة
مما يشير إلى أن هناك احتفالاً يطول المظهر في كلا الجنسين ينبئ بحركة الأسماك الصغيرة في الماء. وما نحن ........التفاصيل
|
|
جامعي بلا عمل: المسيار ليس لأمثالي!! نحن مطاردون بكلمة "عوائل"! | 
* الرياض مجلة الجزيرة
أن نقدم المقهى يعني أن نغامر.
المقهى المتعدد والمختلف في كل شيء، وأنت تقف على عتباته مأخوذا بالمجتمع الذي تراه يخرج من مكان إلى مكان آخر ويتضح فجأة، بغرابة لا يمكن
إنكارها.
المكان الذي لا يمكن وصفه لا بالفراغ ولا بالشك، لكن حين تكسر الحاجز النخبوي والرسمي تتسع حدقة المفاجأة بأن هناك من ينصت لك وللمجتمع
والثقافة بعيدا عن الأعين، ويمارس الحياة.
الجالس في زاوية ........التفاصيل |
|
|
| السوق المفتوح | 
طعامك لن ينزلق
NON SLIP LAP TRAY
موقع الشراء: www.goldviolin.com
السعر: 95 ،34 دولاراً
* هذا الطبق مغطى بمواد خاصة تمنع انزلاق أي شيء يوضع فوقه، صحون الطعام والملاعق والأكواب ستظل في مكانها ولن تؤرقك مسألة وقوعها على
الأرض من اليوم فصاعدا، وبإمكانك أن تتناول طعامك على السرير أو على كرسي صغير في أي مكان دون قلق.
***
اصنع قهوتك بنفسك 
KRUPS IL CAFFE BISTRO ESPRESSO ........التفاصيل |
|
هل يستغني عنه الإنسان؟ الماء سيد المشروبات.. | يعتبر الماء العنصر الأساسي في حياة الكائنات، ولا يمكن الاستغناء عنه أوالاستعاضة به بأي شكل من الأشكال. كما تعتبر المواد التي تحتوي عليه من
الأساسيات الضرورية للجسم، لذا ينصحنا الأطباء بتناول الماء بكميات كبيرة حتى وإن لم نكن عطشى، وهوالسائل الضروري للحياة والذي لا غنى عنه
ولكن كل شيء يتعلق بالنشاط الفيزيائي والحركي الذي نؤديه خلال اليوم، ففي حالة الراحة والحرارة المعتدلة يخسر جسم الإنسان ما ........التفاصيل |
|
| غياب الأب ومشاعر الطفولة | 
يغيب الكثير من الآباء عن المنزل لساعات طويلة، أو لأيام كاملة، أو أسابيع في بعض الأحيان دون أن يكترث بالنتائج المترتبة على ذلك والتي قد تأتي من
وراء هذا الغياب، فهل غياب الأب عن المنزل مهما يكون زمن الغياب يؤثر حقا على نفسية الطفل؟ وكيف يبدو هذا التأثير على الطفل؟ وكيف يتقبل
الطفل ذلك؟
لاشك أن الأمر يتعلق بطبيعة هذا الغياب وأسبابه ونوعيته، فإذا كان الأب يتغيب عن المنزل بشكل روتيني، ........التفاصيل |
|
السفر.. المتعة والعذاب في حياة الطفل | 
مع قدوم فصل الصيف الساخن بحرارته، والمشرق بشمسه الساطعة. الذي يقترن بالعطلة الصيفية للمدارس وللقطاع التعليمي.. تزداد الحاجة إلى السفر
ويتوق الناس إلى التنقل خاصة إلى خارج المدينة لاستغلال العطلة وطمعا في قضاء وقت من الراحة والاستجمام بعيدا عن المتاعب والمشاغل اليومية التي تنكد
حياة المرء خلال السنة.
ولكن كيف ينظر الطفل إلى هذا الموسم؟ وما هو تأثير السفر عليه؟ فالسفر يؤثر على الطفل ........التفاصيل
|
|
| كيف تختارين مزهريات منزلك؟ | 
مع إطلالة فصل الصيف الحار، وظهور أنواع متعددة للزهور الربيعية والصيفية، بروائحها الزكية وألوانها الجذابة، تتزايد الحاجة إلى الأواني التي تحتضنها
وتحميها وتغذيها، ولعل انتشار هذه الأواني وتنوع أشكالها، وطبيعة المادة المصنوعة منها، تعطي أهمية خاصة لإعداد المزهريات التي تدخل في ديكورات المنزل
حيث التناسق والانسجام في الألوان وفي الأحجام بين الزهور والأواني الحاضنة يصبح من أولويات عملية ........التفاصيل |
|
طرق حديثة لإنارة المنزل | 
يكتسب توزيع الإنارة في المنزل بشكل دقيق أهمية كبيرة على صعيد الصحة العامة وصحة العيون باعتبارها أغلى ما يملكه الإنسان في حياته، فتوزع الأضواء
والمصابيح الثابتة والمعلقة في أماكن مختلفة من المنزل، وتؤدي ربة المنزل دورها في توزيعها واختيار النوعية المناسبة للإنارة بحسب المكان المحدد. وتقوم بإعداد
المكان وتجهيزه ويتيح توفر الأعداد الكبيرة من وسائل الإنارة حرية الاختيار والحصول على الأفضل ........التفاصيل
|
|
| المواد البرونزية وسر الأناقة | 
تتعرض مقتنيات المنزل المصنوعة من مادة البرونز إلى تغيير في اللون أو إلى تلف بعض الأجزاء السطحية منها، نتيجة تعرضها لأشعة الشمس أو لتغيرات الجو،
وعوامل الطبيعة، وتقلباتها، ونظراً لحساسية هذه المادة وبخاصة الطبقة السطحية منها، فإن التعامل معها وطريقة تنظيفها، تتم بعناية فائقة، وبلطف شديد،
فهي تتأثر بأقل خدش أو احتكاك، ويمكن العناية بالمواد البرونزية بسهولة ونحتاج إلى مواد بسيطة كي ننجز ........التفاصيل |
|
|
| رحلة اسمية إلى المريخ | أعلن المختبر الروسي لأبحاث الفضاء الطبية عن قيامه بتجربة جديدة لاختبار قدرة طاقم سفينة الفضاء على السفر في رحلة إلى المريخ والعودة بنجاح. وسيتم
اختيار ستة من رواد الفضاء وعزلهم في نظام يحاكي البيئة الفعلىة للرحلة وذلك لمدة 17 شهراً.
يقول "ديمتري مالاشينكوف". من معهد المسائل الحيوية والطبية في موسكو (آيبي إم بي). أنه على هؤلاء الرواد المختارين أن يتعاملوا مع ما يتعرضون إليه من
مواقف كأنهم في ........التفاصيل |
|
كيف يعمل جهاز إنذار ملصقات السلع | 
اعتاد كثير من ضعاف النفوس عند ولوجهم المحال التجارية الكبرى واسواق التبضع على سرقة واخفاء ما خف وزنه وقل ثمنه، ويعمد هؤلاء على وضع هذه
المسروقات في أماكن يصعب رؤيتها من قبل البائع. وأشار كثير من التجار إلى أن هذه الممارسة تضر كثيرا كونها عادة ما تؤدي إلى تعرض المتاجر إلى
الخسارة، كما أن تعرض الزبائن لعملية التفتيش التقليدية تؤثر على مسألة الثقة التي يجب أن تتوفر بين الطرفين كما تضر ........التفاصيل
|
|
| المعايير الآمنة للرصاص تدمر ذكاء الأطفال | 
* إعداد سناء عيسى
كشفت دراسة جديدة أنه حتى التعرض إلى الكميات "الآمنة" من الرصاص يضر بذكاء الأطفال، وأثبتت أن التأثير السلبي للرصاص على ذكاء الأطفال
يتناسب طرديا مع نسبة الرصاص في الدم وذلك عندما تكون نسبة الرصاص في الدم منخفضة عن المعاييرالآمنة!! وذلك يعني أن أغلب الضرر يحدث قبل أن
يصل منسوب الرصاص في الدم إلى أقصى منسوب له.
ويقول "بروس لانفير"، طبيب أطفال في مستشفى الأطفال ........التفاصيل |
|
بطاريات النظائر المشعة.. عشرات السنين من الطاقة المتواصلة | 
* إعداد هدى حسن
تطوير جديد يحسب لصالح الطاقة المتجددة وطويلة الأجل، إذ تستطيع البطاريات الصغيرة التي تحصل على الطاقة من النظائر المشعة النشطة أن تؤمِّن 50
عاما من الطاقة للأجهزة الدقيقة والمعدات الإلكترونية كما يقول مخترعوها.
ويتم شحن هذه البطارية عن طريق نقل نيكل النظير المشع النشط 63. "من الممكن صنع أجهزة حساسة إلكترونية دقيقة جدا يمكن زرعها في الأبنية أو حتى
في الأجسام" كما يقول ........التفاصيل
|
|
| براكين الماء | 
البراكين الموجودة بعيدا عن المسطحات الأرضية حيَّرت العلماء لسنوات طويلة، وقد اعتقد الكثيرون أن المواد المنصهرة والحمم تتدفق من أعماق الأرض
الملتهبة في المناطق شديدة السخونة في صورة البراكين، وقد قام باحثان حديثاً بإلقاء الشكوك حول صحة هذه النظرية.
يتفق علماء البراكين عامة على أسباب حدوث البراكين على المسطحات الأرضية، حيث تتولد الحرارة العالية والحمم البركانية من احتكاك وانزلاق الكتل ........التفاصيل |
|
أبرد السطوحى في المجموعة الشمسية نبتون.. كوكب العواصف العملاقة والبراكين النشطة | 
* القاهرة علي عبد الجواد
مرت سفينة الفضاء فويجر بجوار كوكب نبتون في 24 أغسطس 1989 والتقطت كاميراتها الاف الصور للكوكب السيار الثامن في المجموعة الشمسية
وقمره الاكبر تريتون الذي يبلغ حجمه 4 ،3 حجم قمر الارض وأرسل فويجر هذه الصور إلى الارض من على بعد7 ،2 بليون ميل قبل انهاء مهمته
والاختفاء في الفضاء الخارجي.
عواصف عملاقة
وأظهرت بيانات فويجر ان نبتون هو اكثر كواكب المجموعة الشمسية ........التفاصيل
|
|
موسوعة العلماء ابن النفيس (607 687 هـ) | 
هو أبو الحسن علاء الدين علي بن أبي الحزم الذي يكنى بابن النفيس، كان طبيبا وفيلسوفاً كبيراً، وُلد في دمشق سنة 607 للهجرة ودرس فيها الطب بعد
أن تتلمذ على يد كبار علماء تلك الحقبة الزمنية التي شهدت تميز العلماء العرب، هاجر إلى مصر التي كانت تشتهر بأكبر ميادين ممارسة العلم، فعمل بها
بالمستشفى الناصري ومنها إلى المستشفى المنصوري الذي اصبح عميدا لأطبائه، وعمل أيضا في وظيفة الطبيب الخاص ........التفاصيل |
|
أحدث إختراع علاج سرطان الدم باستزراع خلايا جذلية |
نجح فريق أطباء مستشفى "تونغجي" بمقاطعة هوبي وسط الصين في التوصل الى علاج جديد لمرض اللوكيميا (سرطان الدم) باستخدام تقنية حديثة يتم في
إطارها استزراع خلايا جذلية مكونة للدم من غير نخاع العظام فيما يمثل إنجازا علميا غير مسبوق يفتح أبواب الأمل على مصراعيها أمام الملايين من مرضى
سرطان الدم والذي يحتل المركز الثالث على قائمة الأورام السرطانية المسببة للوفيات على مستوى العالم بعد سرطان ........التفاصيل
|
|
|
|
ليس بالمال وحده تضمن حفز العاملين أحدث 3 أدوات لشراء "الأداء" العالي! | 
* إعداد أمجد الجباس
عادة ما تمر الشركات بأوقات عصيبة تعجز خلالها عن أن تقدم لموظفيها الحوافز المالية التي تضمن ولاءهم وتشجعهم على الإبداع والابتكار.
وإذا كان من الطبيعي أن يتنقل العاملون من شركة إلى أخرى بحثا عن الراتب والمزايا النقدية والعينية الأفضل، إلا أن بعض الدراسات تظهر أن النقود ليست
هي السبب الرئيسي وراء تمسك العاملين بالبقاء في شركة من الشركات على الرغم مما قد تعانيه من ظروف ........التفاصيل
|
|
دراسة حول توظيف المفأجأة كأداة تسويقية ابعد عن "تقليد" الآخرين | 
في الوقت الذي تسعى فيه الشركات إلى إقامة علاقات وطيدة مع عملائها تقوم في جانب كبير منها على وجود علاقة ارتباط وولاء عاطفي بين الطرفين،
تحاول الشركات أن تعتم على عنصر "المفاجأة" ضمن الأدوات التسويقية التي تستخدمها من أجل كسب رضا وولاء العملاء، وقد كان استخدام عنصر
المفاجأة كأداة تسويقية موضوعا لبحث قام به آدم ليندجرين، أستاذ مساعد التسويق بجامعة إيدنهوفين للتكنولوجيا بهولندا والذي قام ........التفاصيل |
|
يحلّق على أطراف الملعب بسرعة ورشاقة أوفر مارس .. الطائر الهولندي | 
إعداد : خالد الطياش
بطاقة اللاعب الشخصية
* الاسم: مارك أوفر مارس
* تاريخ الميلاد: 29/3/1973م
* الجنسية : هولندي
* الطول: 173 سم
* الوزن: 72 كجم
* المركز: جناح مهاجم
* الحالة الاجتماعية: متزوج
مارك اوفر مارس الجناح الأسرع في العالم جريا بالكرة، لاعب سريع ومهاري يجيد اختراق الدفاعات ويمتاز بالتلاعب بمدافعي الخصم، يعود للخلف ويستلم
الكرات من زملائه لينطلق بها للأمام كالسهم حتى ........التفاصيل
|
|
| بيكهام ينضم لكوكبة ريال مدريد | 
بعد انتقاله لفريق ريال مدريد الأسباني في عقد مدته 4 سنوات بلغت قيمته 35مليون يورو صرح النجم الانجليزي الدولي وكابتن المنتخب ديفيد بيكهام بأنه
سعيد بالانتقال لفريق مليئ بالنجوم وينافس على جميع البطولات الأوروبية والعالمية وأشاد بمدربه السابق أليكس فيرغسون وبتعامله معه ككابتن للفريق وتمنى
لمانشيستر يونايتد ولجماهيره التوفيق في تحقيق البطولات مستقبلا وسلم شارة القيادة لزميله روي كين ........التفاصيل |
|
متفرقات رياضية سريعة | * أكد نادي مالاقا الأسباني بأنه ليس لديهم النية في تجديد عقد مدرب فريق كرة القدم جوكين بيرو، صرح بذلك رئيس النادي سيرافين رولدان وتمنى بأن
يكون ذلك القرار هو الأفضل لكلا الطرفين مستقبلا وأن لايكون قرارا خاطئ ينتج عنه ضرر الفريق.
وصرح المدرب العجوز والبالغ من العمر 67 عاما بأنه حزين لهذا القرار خاصة وان أنصار النادي يرغبون في استمراره ولا يوجد أي مشاكل مع مد راء
ورئيس النادي ولكنهم اعتقدوا ........التفاصيل |
|
| صفقة جديدة لليدز يونايتد | 
كشف رئيس نادي ليدز يونايتد بأنه سيتعاقد مع نجم المنتخب الإنجليزي تحت 21عاما جيرمين بينانت في حال بيعه لمهاجم ليدز هاري كيول، هداف الفريق
الشاب والدولي الأسترالي موضحا انه مطلوب من قبل عدة اندية كبيرة ويدرس نادي ليدز حاليا العرض المقدم له من قبل مانشيستر يونايتد وليفربول
بالإضافة للآرسنال، ويحاول ليدز أقناع هاري كيول بتمديد عقده حيث يبقى له مدة سنه حتى ينتهي عقده، بعد ذلك يعتبر حرا في ........التفاصيل |
|
شيفشنكو "ممنوع" من البيع ومفاوضات توتي باطلة | 
نفى نائب رئيس اي سي ميلان الإيطالي ما نشر في الصحف ووسائل الإعلام حول مفاوضة الميلان لنجم وقائد نادي روما الإيطالي فرانشيسكو توتي وقال
"لم نفاوض توتي ولم نتحدث معه او مع نادي روما بأي شيئ ، نحن نعرف أن توتي مرتبط بعقد مع ناديه ويستحيل التعاقد معه بدون موافقة النادي حتى
وان رغب توتي في ذلك "ويذكر أن هناك تقارير أفادت بأن الميلان عرض نجميه روي كوستا وريفالدو مقابل توتي". ومن جهة أخرى ........التفاصيل
|
|
| عمرو دياب.. والشروط الفضائية!! | إعداد: تركي بسام
قيل ان الفنان عمرو دياب يود الانتقال من "عالم الفن" الى شركة "روتانا" بشرط ان تساعده الاخيرة في اقامة قناة فضائية تختص بفنه.. وكان عمرو دياب
شريكا مع محسن جابر في قناة مزيكا.
السؤال الحائر.. والدائر.. بأذهان الناس هل عمرو بهذه الاهمية ليشترط انشاء قناة فضائية خاصة بفنه وترضخ له الشركة؟
وماذا يحدث لو ان كل فنان مثل عمرو او فوق مستواه سار على نفس النهج هل الفضاء من حولنا سيسع ........التفاصيل |
|
فضائيات تزايد القنوات.. لا جديد | ما ان تستيقظ صباحا حتى تطل عليك قناة تلفزيونية جديدة وأياً كان نوعها اخبارية او منوعات او موسيقى فالكل يتشابه هذه الايام لدرجة انك قد تكون
جالسا امام شاشة احدى القنوات ولا تعرفها ولا تميزها عن غيرها فالكل واحد الفكرة والديكور والاضاءة ومَنْ المستفيد؟ بالتأكيد المتضرر الوحيد هو
المشاهد العربي الذي تستهدفه كل هذه القنوات وهو الضحية الوحيد بينها وسط تنافس غير شريف على الاطلاق.
لقد اصبح من السهل ........التفاصيل |
|
| كارين سلامة: لا أواجه الكاميرا.. لأنني لست وقحة | 
بدأت كارين سلامة مشوارها التلفزيوني مصادفة حيث كانت تحضر اختبارات المتقدمين ودخلت الاختبار واجتازته وانتقلت من تخصص حضانة الاطفال
الى مذيعة في تلفزيون "المستقبل" كارين سلامة بدأت حياتها في الاعلام بالعمل في محطة ارضية وبعدها الى قناة المستقبل وتعمل بكل ثقة وثبات وتحسب
خطواتها بكل دقة فهي تعتقد ان لكل مرحلة نجاحاتها وانها قد حققت نجاحات مرحلتها وتسير في الطريق الصحيح نحو العالمية ........التفاصيل |
|
تنقل المذيعات خيانة ام احتراف؟ | درجت الفضائيات العربية وضع بصمات خاصة بكل منها وظلت كل قناة تتميز من خلال برامجها، او العناصر الاعلامية العاملة لديها.. وفي هذا المعترك
شكل الاعلاميون فرس الرهان.. واخذت كل محطة تحرص على كوادر وكفاءات معينة توفر لهم الامان وتحقق لهم الرضاء الوظيفي لتضمن عطاءهم الذي
يقودها الى التفوق والتفرد.
وحول.. الكوادر والكفاءات دار الصراع.. وحول الرواتب والاستحقاقات والامان والرضا والحوافز والاغراءات دب ........التفاصيل |
|
| إنه زمن أليساء.. وهيفاء!! | 
الكثير من الفضائيات ظلت تقدم الاغاني الهابطة الخالية من المضمون.. لا كلمات.. ولا ألحان.. ولا رسالة فنية.. ولا.. ولا.. فقط مجرد عرض ازياء.. او ما
تحت الازياء.. ورقصات فاضحة وتفريغ للفن من اي معنى يمكن ان ينسب اليه.. والمتتبع للقنوات العربية الحائرة والخاوية من البرامج والمواد القيمة يراها
تقدم أغانٍي اقل ما يمكن ان توصف به انها تدل على حالة الإحباط والتدهور والسقوط مثل اغاني أليساء.. ........التفاصيل |
|
القنوات الإخبارية..حاجة أم تقليد؟! | تصاعدت ظاهرة القنوات الاخبارية المتخصصة، حتى صارت لافتة لنظر المشاهد.. بدأت المسألة بقناة الجزيرة الاخبارية التي تخصصت منذ نشأتها وتفردت في
هذا المضمار خلال عقد من الزمان ثم قناة "العربية" واخيرا ظهر التعاون القوي بين جريدة الحياة وقناة LBC، هذا التعاون الذي ظهر خلال الحرب ضد
العراق، ومن الجانب الآخر تعد قناة "ابوظبي" لتخصيص قناة اخبارية جديدة لتعمل مع مثيلاتها في نفس المجال.. كل هذا الاهتمام ........التفاصيل |
|
| عودة دراما التاريخ.. بدون أخطاء!! | 
يستعد العديد من الفنانين الذين ارتبطت أسماؤهم بالدراما التاريخية لتقديم المزيد من الاعمال الجديدة كأيمن زيدان وأسعد فضة وجمال سليمان وسلوم حداد.
وبالرغم من نجاح هذه النوعية من الدراما وبالرغم من وجود العديد من التساؤلات حولها الا اننا نتوقع ان يركز هؤلاء الفنانون على صياغة المادة التاريخية
كمادة حدثت فعليا ويتعاملون معها على هذا الاساس ولا تجبرهم المقدرات والنواحي الفنية لمحاولة تغيير ........التفاصيل |
|
أخبار سريعة | * بدأت الممثلة الإماراتية هدى الخطيب تصوير مشاهدها في المسلسل التلفزيوني الجديد "لن أنسى" وهو من تأليف مهدي الصايغ واخراج رمضان علي
ويتكون المسلسل من ثلاثين حلقة.
* للمرة الأولى اعترف الممثل الكويتي احمد الجوهر بأن جزءاً من حلقته التي شارك فيها عبر البرنامج الكويتي "صادوه" كانت مفبركة.. وهو يستعد حالياً
لتطوير مسلسل جديد باسم "الاخطبوط".
* تقوم المطربة الإماراتية رويدا المحرقي بإعداد ........التفاصيل |
|
قوة.. أم ضيوف شرف؟ الفنان السعودي.. والمشاركة الخارجية | 
ازدادت في السنوات الأخيرة مشاركة الفنانين السعوديين ضمن الأعمال العربية السورية منها والمصرية حتى غدت ظاهرة واضحة للعيان.. ولكن ما سبب
إصرار بعض الشركات المنتجة على إشراك وجوه سعودية في الأعمال التلفزيونية.. هل السبب هو موهبة الفنان السعودي.. أم هي ضرورات إنتاجية ولعبة
تسويقية بدأت ترفضها حتى جهات الاختصاص في المملكة التي أعلنت رفضها لأي عمل يشارك فيه ممثل سعودي ما لم يكن هذا الممثل ........التفاصيل |
|
موعد سهام جلال | 
تدرس الممثلة الشابة سهام جلال سيناريو وحوار الفيلم السينمائي الجديد الذي يحمل عنوان "موعد" وهو من تأليف إبراهيم أبوزيد واخراج محمد نور
ومرشح لبطولته انعام سالوسة وطارق لطفي وتلعب سهام جلال دور مضيفة جوية تعاني من مسألة الجمع بين الزواج والعمل وتدور أحداث الفيلم في هذا
المحور. وتبلغ ميزانية الفيلم حوالي ثلاثة ملايين جنيه.........التفاصيل
|
|
| مرح جبر: جديدي لا يمكن الإفصاح عنه الآن | 
مرح جبر ممثلة سورية صاعدة، حبها للعمل الفني، ونظرتها إلى العلياء قربت المسافة بينها وبين النجومية، وبالرغم من أعمالها المتميزة، والناضجة فهي تعتقد
ان المسؤولية اكبر من ذلك، وان النص الجيد والمميز هو الحافز الأساسي نحو التقدم إلى الأمام وإلا فالأفضل التوقف والحفاظ على المستوى المعروف.
قامت مرح بأعمال عديدة، ومتنوعة، وجعلت التميز عنوانا لمشوارها.. استضفناها في هذه المساحة لمعرفة المزيد ........التفاصيل |
|
سيناريو | * ممثلة تلفزيونية معروفة قامت بصفع عامل الديكور على وجهه بقوة.. وهي في ثورة غضبها إثر سقوطه عليها بينما كان يشير إلى زميل له لضبط إحدى
قطع الديكور، حيث اختل توازنه وسقط من على الاريكة على الممثلة المعروفة.
* نجم شاب ذو قوام رياضي تألق مؤخراً في بطولة مسلسل تلفزيوني كبير.. أدى اعجاب الجمهور به إلى إثارة غيرة طليقته التي شعرت بحجم الخسارة لفقده
رغم انها كانت هي المصرة على الطلاق.
*مذيعة ظلت ........التفاصيل |
|
أغنية "راضي" | *كلمات وألحان: خالد عبدالرحمن
* غناء: أحلام
رغم أن الفنان خالد عبدالرحمن فنان مميز إلا أنه أيضاًَ أحد الشعراء الذين يكتبون بإحساس مرهف.
لذلك فهو يكتب القصيدة المتميزة بإحساس الفنان، وله تعاونات كثيرة مع عدد من الفنانين وكان له تعاون مع الفنانة "أحلام" بعنوان راضي:
راضي بحبك وانت بالحب راضي
عدونا لا شافنا بخير يغتاض
صدق المشاعر مات من يوم قاضي
دام العطا من بيننا حيل فياض
قبل امس ولى صار ........التفاصيل |
|
شوارزينجر يأمل في إنقاذ كاليفورنيا | في فيلمه المدوي المقبل "المبيد الجزء الثالث" ينقذ الرجل القوي الكبير في السن والنجم السينمائي أرنولد شوارزينجر العالم من جيوش كائنات آلية شريرة
تتخذ صورة البشر.
وفي حياته الحقيقة، لا تبدو طموحات شوارزينجر أقل بكثير من ذلك، فكل المؤشرات تدل على أن بطل الفيلم النمساوي المولد يستعد لإعلان خوض
الانتخابات عن الحزب الجمهوري للمنافسة على منصب حاكم كاليفورنيا.
وهذا ليس بإنجاز رديء لرجل يعتبره معظم ........التفاصيل |
|
| أشهر عشرة أفلام في شباك التذاكر الأمريكي هذا الأسبوع |
(10) X2:XMen United
(خيال علمي)
* يعود أبطال الجزء الأول من جديد لإكمال رحلة كفاحهم ضد المجتمع الذي رفضهم بسبب قواهم الغريبة التي تميزهم عن غيرهم.هذه المرة سيتحد الجميع
بعد خروج "ماجنيتو" من سجنه لمواجهة ضابط عسكري يستهدف هؤلاء الغرباء وينوي القضاء عليهم نهائيا.
(9) Daddy Day Care
(كوميدي)
* يفقد إدي ميرفي عمله في إحدى الشركات الكبيرة وخوفا من الفقر يقرر أن يحول منزله لحضانة. ويتعاون مع ........التفاصيل |
|
العملاق الأخضر يعود للسينما | 
بدأ قبل أيام العرض الأول لفيلم العملاق الأخضر HULK وهو فيلم مقتبس من قصص مرسومة شهيرة وسبق وأن عرض على شاشات التلفزيون خلال فترة
السبعينيات وحتى بداية الثمانينيات ونال شهرة كبيرة في ذلك الوقت.
وحان الوقت اليوم لإعادة هذا العملاق من جديد فظهر لنا الفيلم الذي طال انتظاره تسبقه إعلانات مستمرة على كل وسائل الإعلان ويبدو أنه سيتربع
على عرش الأفلام العشرة الأولى لفترة ليست قصيرة.
ورغم أن ........التفاصيل
|
|
البحث عن نيمو Finding Nemo (كارتوني / عائلي) مغامرة خاصة في رحلة البحث عن سمكة! | 
يجوب ذكر سمك المحيط الواسع بحثا عن ابنه المفقود وفي مشوار بحثه يحصل على بعض العون وينطلق في مغامرة ممتعة وجديرة بالمشاهدة.
القصة هي كل شيء
مهما كان حجم الدهشة التي تثيرها الصور المتحركة المعالجة بالكمبيوتر، فإن سر نجاح أي فيلم لشركة "بيكسار" يكمن وراء القصص العظيمة التي ترويها
تلك الأفلام، ولا يعتبر "البحث عن نيمو" استثناء من القاعدة.
يدور الفيلم حول أحد ذكور الأسماك الفظة ويدعى ........التفاصيل |
|
مطابخ الصيفية عنوان للراحة والجمال | 
إعداد: تنكزار سفوك
مع إطلالة فصل الصيف البهي بجلساته الليلية الحالمة، يجتمع أفراد العائلة في حديقة المنزل أو يستقبلون ضيوفهم في هذه الجزء المنعش من المنزل، فتزداد أهمية
الأجزاء الخارجية من المنزل كالحديقة والمسبح.. وكان لابد من مطبخ يفي بحاجة الأسرة يعوض عن المطبخ الداخلي ويحقق الراحة في موقع قريب من أماكن
الجلوس والسهر.
ورغم أن هذا المطبخ حديث العهد إلا أن أهميته تنبع من كونه يقدم ........التفاصيل
|
|
| وظائف عملية وجمالية للسلالم الداخلية | تستخدم السلالم الداخلية لغايات عملية تتمثل في ربط غرف النوم الواقعة في الجزء العلوي من المنزل مع الصالون، وتتحكم في أشكالها الهندسة الداخلية
للمنزل، وتكون بأشكال مختلفة، فمنها الدائرية أو المستقيمة أوالمنحنية.. وهي تدخل اليوم ضمن المكونات الأساسية التي يحرص عليها مهندسو الديكور
لتفعيل الأجزاء الحيوية من المنزل، باعتبارها جزءا مهما من العناصر الجمالية فيه، وتأخذ حيزا كبيرا من الصالون ذلك الجزء ........التفاصيل |
|
اصنعي بنفسك أزهار طبيعية | 
من المقتنيات التي يحتاجها المنزل بكثرة في فصل الصيف، الزهور الطبيعية التي تلعب دوراً كبيراً في إنعاش المنزل بالروائح الطيبة، وفي إضفاء المزيد من الجمال
على أجزائه المختلفة، ولا يحتاج عمل مزهرية من الزهور الطبيعية إلى كثير من الجهد أو التعب، فالعمل بسيط و سهل.
ومن مستلزمات هذا العمل: إناء زجاجي متوسط الحجم، لفافة من الخشب تستخدم كديكور للإناء، شبك من الأسلاك الناعمة، وزهور ونباتات حسب ........التفاصيل
|
|
| الأثاث المعدني يتربع على عرش الديكور | 
بدأ الأثاث المعدني يكتسب أهمية كبيرة في دنيا الديكورات المعاصرة، ولم يعد المعدن من المواد التي تدخل في صناعة المفروشات أو الإكسسوارات المنزلية
بصورة جزئية، وإنما أصبح واحدا من المواد التي يصنع منها أثاث المنزل بمختلف أنواعه و أشكاله، وأصبح له من الأهمية ما يوازي أهمية المواد الأخرى
كالخشب والزان، وله طابعه الخاص في جعل ديكورات المنزل عنوانا لجماله ورقيه.
وهو يكاد يدخل في صناعة كافة ........التفاصيل |
|
لترتيب ديكور الطاولة أصول | 
تدخل ديكورات طاولة الطعام ضمن دائرة اهتمام الأسرة، التي تسعى لأن تقدم هذه الزاوية من المنزل في حلة جميلة، وتجعل منها مكانا لاستقبال الضيوف،
من خلال الاختيار الصحيح للديكورات، والتغير والتبديل الذي نجريه بين الحين والآخر على الأجزاء المكونة لها، ولاشك أن هذه الديكورات تغني
بالأفكارالجديدة في عالم الأسرة و باللمسات التي يضيفها أصحاب المنزل على ترتيب الطاولة وتحضيرها لتكون مائدة معدة ........التفاصيل
|
|
| إكسسوارات حديثة للمنزل الأنيق.. | 
يحتاج المنزل الحديث إلى إكسسوارات عديدة تزين بها مقتنياته كالطاولات في الصالون أو بعض رفوف المكتبة أو زواياها، و من هذه الإكسسوارات الأواني
الزجاجية التي تستخدم في احتواء الزهور أو تستخدم بدونها حيث تشكل هذه المقتنيات زينة للمنزل ولأجزائه .
ونستعرض هنا عددا من هذه الأواني المختارة والعصرية بأشكالها وألوانها :
1 إناء من الكريستال في شكل كأس كبير الحجم والصورة، منقوش بصور وخطوط دائرية ........التفاصيل |
|
قتل جدته ليسرق مصوغاتها! جنون الذهب | كان الليل قد انتصف منذ ساعات والسماء حالكة السواد عندما تسلل إلى سطح أحد المنازل بالحارة ومنه قفز إلى سطح المنزل المجاور..لم يهبط إلى الأسفل
وإنما جلس على السلم في انتظار سماع صوت آذان الفجر.. صاحبة المنزل اعتادت الاستيقاظ في الفجر لأداء الصلاة ويمكن أن يغافلها عندما تذهب للوضوء
ويستغل غيابها عن حجرتها في التسلل للحجرة وسرقة ما بها من نقود ومصوغات ذهبية قليلة ثم يغادر الحجرة دون أن تشعر به أو ........التفاصيل |
|
"وصية" الدماء الخلافات القديمة والطمع دفعاه لقتل زوجته | نعم..قتلتها ولست نادما على ذلك.. لأنها سبقت وان قتلت رجولتي وأضاعت كرامتي بين أهلي وجيراني.
ولو عادت إلى الحياة لقتلتها من جديد، بذلك اعترف قاتل زوجته بالإسكندرية والذي أعماه الطمع عن حقيقة كانت غائبة عنه وهي أن زوجته الأولى على
قدر كبير من الذكاء والفطنة.. بعد أن طلقها لفترة طويلة امتدت إلى 10 سنوات عاد إليها متظاهرا بحبه والرغبة في استئناف حياتهما الزوجية من جديد
لأجل عيون الولدين لكنه في ........التفاصيل |
|
القتل للمتعة !! | أثارت حديقة طبيعية في منطقة داندونغ بمقاطعة لياونينغ بشمال الصين الانتقادات بعد سماحها للزائرين باستخدام البنادق الحقيقية في صيد الدجاج الصغير
على سبيل المتعة والبهجة. ويقول المقيمون بالمنطقة ان عمليات اطلاق النار على الدجاج اثارت الانزعاج في نفوس الاطفال الذين يزورون الحديقة فضلا عن
الانواع المحمية من الطيورالموجودة بالقرب من الحديقة وفق ما ذكرته صحيفة "بكين ايفننج نيوز" الصينية.
وقال مسئول ........التفاصيل |
|
وهكذا دواليك ديوك عبدالباسط شاطرابي | كل الديوك غبية. هذا ليس استنتاجاً ولكنه إحساس.
صدقوني كلما رأيت ديكاً أحسست أن الغباء يتصاعد من رأسه دخاخين دخاخين!!
أنظرُ إلى عيني الديك فأحس بالبلاهة في نظراته..
أراه وهو يمشي منتشياً فأحس أنه منفوخ على الفاضي!! أشاهده وهو يبحلق.. في الأرض باهتمام عجيب فأحس أنه يبحلق في اللاشيء!!
المصيبة أن الديك يحاول أحياناً ممارسة السطوة على الدجاج من الإناث، فتراه يصيح مزهواً بقوة صوته أمامهن، ........التفاصيل |
|
بعد نجاح كتابها "التاريخ الحي" هل تخوض هيلاري كلينتون سباق الرئاسة لعام 2008 ؟! | 
* واشنطن جيل روسيل تشادوك(*)
تجمع حشد من الناس خارج مكتب هيلاري كلينتون بشكل سريع وهم يتدثرون بأغطيتهم بانتظار ظهور المذكرات على ارفف المكتبات في الوقت الذي
تسربت فيه انباء بأن السيدة الاولى السابقة بصدد الحديث عن بعض ماورد في مذكراتها وضم الحشد عدداً من السائحين والطلبة والصحفيين.
تقول شيري ستيورات من بورتلاند بولاية اورليانز في معرض وصفها للسيدة هيلاري كلينتون: "ان لها شخصيتها ........التفاصيل
|
|
| كومبيوتر ببطن سمكة!! | 
فوجئ لاري ماتسون من ولاية منيسوتا الامريكية بوجود جهاز كومبيوتر صغيرفي بطن سمكة سلمون بعد فتح بطنها واتصل برقم تليفوني كان مكتوبا على
ظهرها فردت عليه لجنة الحياة البرية والاسماك بالبحيرات العظمى الهندية التي قامت بزرع 124 جهاز كومبيوتر صغيرفي هذه الاسماك في نوفمبر عام 2001
وفقا لما ذكرته شبكة سي نيوز. واشارت الشبكة الاخبارية إلى انه تم استخدام اجهزة الكومبيوتر في تسجيل عمق المياه ........التفاصيل |
|